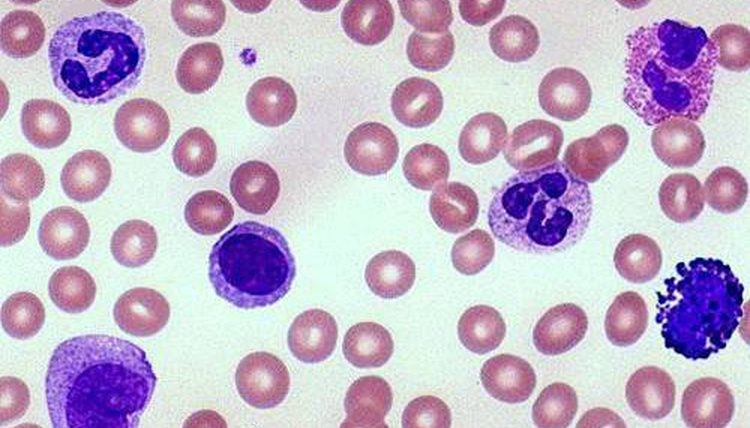
leucocitos-bajos-

¿Por qué tengo los leucocitos bajos?
Tener los leucocitos bajos es una afección que afecta diariamente a millones de personas en el mundo. Más que una enfermedad, se trata de un síntoma que puede ser consecuencia natural de algún otro tipo de afección.
Si en un reciente examen sanguíneo descubriste que tus glóbulos blancos están por debajo de los valores normales de leucocitos, aquí podrás conocer las patologías más comunes que producen este síntoma.
Enfermedad autoinmune
Enfermedades autoinmunes como el lupus erimatoso sistémico, por ejemplo, pueden alterar los valores normales de leucocitos, provocando un nivel bajo de glóbulos blancos en la sangre. Esto se debe a dicha enfermedad provoca que el sistema inmune considere a los leucocitos como una amenaza para el organismo, de manera que opte por destruirlos.
Enfermedades primarias
Se pueden listar enfermedades primarias como artritis reumatoide, dengue, déficit de cobre, zinc, tuberculosis, sida, malaria y gripe como autoras de la leucopenia como efecto secundario. En estos casos es de vital importancia encargarse de las enfermedades para que se alcancen los valores normales de leucocitos.
Problemas con la médula ósea
Por otra parte, diversas enfermedades que afectan al funcionamiento de la médula ósea pueden provocar que se alteren los valores normales de leucocitos, ya sea porque la médula no produce tantos como debería o produce demasiados de un solo tipo, provocando un déficit de glóbulos blancos en consecuencia.
Entre las enfermedades de la medula que pueden generar una sintomatología de leucocitos bajos se destacan la anemia, el síndrome mieloproliferativo, el síndrome mielodisplásico, el déficit de folato y vitamina B12 y la leucemia